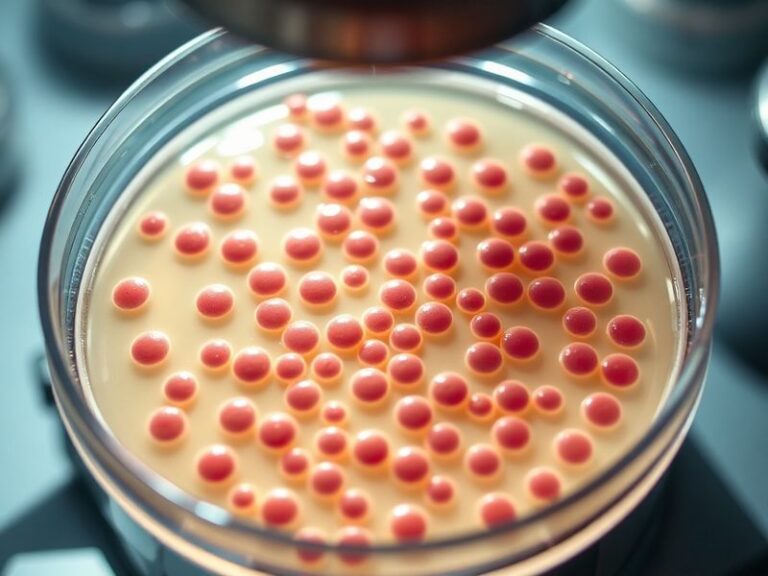
A medical professional in protective gear examines a petri dish containing Shigella bacteria under a microscope in a sterile

Drug-Resistant Shigella: A Growing Public Health Threat
<!DOCTYPE html> <html lang="en"> <head> <meta charset="UTF-8"> <meta name="viewport" content="width=device-width, initial-scale=1.0"> <title>Drug-Resistant Shigella: A Growing Public Health Threat</title> </head> <body> <article> <h1>Drug-Resistant Shigella: A Growing Public Health Threat</h1> <p>Shigellosis, an infectious disease caused by the Shigella bacteria, has long been a concern for public health officials. However, the rise of drug-resistant strains is transforming this…